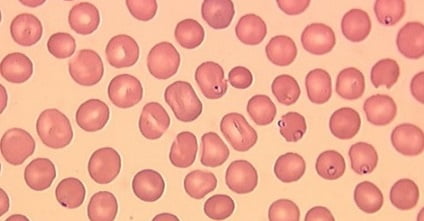

Гемолитическая анемия — что это такое, клинические рекомендации и способы лечения
Гемолитическая анемия (ГА) — это ряд редких, но поддающихся диагностике и лечению болезней крови, во время которых начинается усиленное разрушение эритроцитов. ГА, которые обусловлены внутрисосудистой деструкцией, появляются в результате действия токсинов, сильных ожогов, заражении крови, переливании неподходящей по группе и резусу крови. Влияют и иммунопатологические процессы.
ГА со внесосудистой (внутриклеточной) деструкцией, обладает наследственной природой. Разрушение эритроцитов проходит чаще в макрофагах селезенки, реже в костном мозге, печенке и лимфоузлах. Вероятно трио: анемия, воспаление селезенки и желтуха. ГА делятся на эритроцитопатии, эритроцитоферментопатии и гемоглобинопатии.
Что это такое?
Гемолитическая анемия — групповое название достаточно редко встречающихся заболеваний, общим признаком которых является усиленное разрушение эритроцитов, обусловливающее, с одной стороны, анемию и повышенное образование продуктов распада эритроцитов, с другой стороны — реактивно усиленный эритропоэз.
Врачи отмечают, что гемолитическая анемия представляет собой серьезное состояние, требующее внимательного подхода к диагностике и лечению. Специалисты подчеркивают, что данное заболевание связано с разрушением эритроцитов, что приводит к снижению уровня гемоглобина и кислородной недостаточности. Врачи выделяют несколько причин гемолиза, включая аутоиммунные реакции, инфекции и наследственные нарушения.
Важно, чтобы пациенты обращались за медицинской помощью при первых симптомах, таких как усталость, бледность и желтуха. Лечение может варьироваться от назначения кортикостероидов до более сложных методов, таких как переливание крови или даже спленэктомия. Врачи акцентируют внимание на необходимости индивидуального подхода к каждому пациенту, так как эффективность терапии зависит от причины заболевания и общего состояния здоровья. Регулярное наблюдение и контроль уровня гемоглобина также играют ключевую роль в управлении этим состоянием.
https://youtube.com/watch?v=yB2jBEY7414
Немного про эритроциты
Эритроциты, или красные кровяные тельца — это клетки крови, главная функция которых заключается в транспортировке к органам и тканям кислорода.
- Формируются эритроциты в красном костном мозге, откуда зрелые формы их выходят в кровоток и циркулируют по организму. Продолжительность жизни эритроцитов равна 100-120 дням. Каждый день часть их, составляющая примерно 1%, погибает и замещается таким же количеством новых клеток.
- Если продолжительность жизни красных кровяных телец сокращается, в периферической крови или в селезенке их разрушается больше, нежели успевает созревать в костном мозге — равновесие нарушается. Организм реагирует на снижение содержания эритроцитов в крови усиленным синтезом их в костном мозге, активность последнего существенно — в 6-8 раз — возрастает.
В результате в крови определяется повышенное число молодых клеток-предшественников эритроцитов — ретикулоцитов. Разрушение эритроцитов с выделением гемоглобина в плазму крови называют гемолизом.
Причины возникновения
Современная наука не предусматривает деление гемолитической анемии в зависимости от места разрушения эритроцитов. В большей степени уделяя внимание этиологии и патогенезу заболевания и, исходя из этих принципов, болезнь делят на 2 основных класса:
- Приобретенные формы ГА, которые классифицируют по фактору, разрушающему эритроциты и вызывающему эту анемию (антитела, гемолитические яды, механическое повреждение).
- Наследственные гемолитические анемии — классифицируются по принципу локализации генетического дефекта красных кровяных телец, из-за которого эритроциты становятся неполноценными, функционально неустойчивыми и не способными жить положенное для них время. В числе наследственных ГА значатся: мембранопатии (микросфероцитоз, овалоцитоз) дефекты ферментов (дефицит Г-6-ФДС), гемоглобинопатии (серповидно-клеточная анемия, талассемия).
Большое количество всех ГА попадает на приобретенные формы, но и среди них существует ряд вариантов, которые, в свою очередь, тоже имеют разновидности, обусловленные отдельными причинами возникновения:
- Развитие гемолитической анемии может запустить дефицит витамина Е;
- ГА развивается по причине соматических мутаций, изменяющих мембранную структуру красных кровяных телец (пароксизмальная холодовая ночная гемоглобинурия);
- Развитие болезни обусловлено влиянием антиэритроцитарных антител, выработанных на собственные антигенные структуры эритроцитов (аутоиммунные — аутоиммунная гемолитическая анемия) или изоантител, попавших в кровь извне (изоиммунная — гемолитическая болезнь новорожденных);
- Негативное влияние на мембранные структуры нередко оказывают различные химические вещества, чужеродные для человеческого организма (органические кислоты, гемолитические яды, соли тяжелых металлов и др.);
- К повреждению мембраны красных клеток крови может привести механическое воздействие искусственных сердечных клапанов или травмирование эритроцитов в капиллярных сосудах стоп при ходьбе и беге (маршевая гемоглобинурия);
- Такой паразит, как малярийный плазмодий, проникающий в кровь человека при укусе комара (самки) рода Anopheles (малярийный комар), опасен в плане возникновения гемолитической анемии, как симптома «болотной лихорадки».
Самой распространенной формой среди приобретенных ГА является аутоиммунная гемолитическая анемия (АИГА).
Гемолитическая анемия вызывает множество обсуждений среди пациентов и врачей. Люди, столкнувшиеся с этой проблемой, часто делятся своими переживаниями о симптомах, таких как усталость, бледность и одышка. Многие отмечают, что первоначально не понимают, что именно происходит с их организмом, и это вызывает страх. Врачебные консультации становятся важным этапом, где пациенты получают информацию о причинах заболевания и возможных методах лечения. Некоторые пациенты рассказывают о своем опыте с различными терапиями, включая медикаментозное лечение и переливание крови. Важно отметить, что поддержка со стороны близких играет значительную роль в процессе восстановления. Люди также обсуждают необходимость регулярного мониторинга состояния и соблюдения рекомендаций врачей, чтобы избежать осложнений.
https://youtube.com/watch?v=ILDeCNxqjCk
Классификация
Все гемолитические анемии классифицируются по такому принципу.
Приобретенные формы — развиваются под определенным влиянием каких-либо внешних факторов, которые оказывают разрушающее воздействие на эритроциты.
- Аутоиммунная гемолитическая анемия;
- Анемии, вызванные механическими эритроцитарными повреждениями или провоцирующим паразитическим, токсическим воздействием веществ.
Наследственные или врожденные формы — являются результатом воздействия на жизнедеятельность эритроцитов генетически детерминированных отклонений.
- Мембранопатии;
- Гемоглобинопатии (серповидно-клеточная анемия, талассемия и пр.);
- Эритроцитопатии (анемия Минковского-Шоффара);
- Ферментопатии.
Симптомы
Гемолитические анемии выражено проявляются в период кризисов. При вялотекущих процессах симптомы смазаны. Определить конкретный вид патологии можно только при помощи дополнительной диагностики.
К основным симптомам относятся:
| Синдром анемии | проявляется в бледности кожи, слизистых. Сопровождается симптомами нехватки кислорода в виде одышки, головокружения, слабости, усиленного сердцебиения. |
| Синдром желтухи | возрастание концентрации билирубина как продукта распада эритроцитов, выражается желтизной кожных покровов, изменением цвета мочи. |
| Гепатоспленомегалия | увеличение селезенки происходит за счет интенсивного гемолиза, может достигать значительных размеров. Печень менее подвержена изменениям. Но в некоторых случаях наблюдается и ее увеличение, сопровождающееся тяжестью в подреберье. |
Гемолитическая анемия может проявляться дополнительными симптомами в виде:
- болей в животе;
- послабления стула;
- болезненности костей;
- повышенной температуры;
- болей в груди и области почек.
Даже если есть только 2 или 3 из перечисленных симптомов, то это должно послужить поводом для врачебного обследования. Ведь токсичный билирубин при длительном воздействии на ткани и органы может нарушить их функции.
https://youtube.com/watch?v=GMvJtx4iiMk
Клинические формы
В клиническом проявлении можно выделить несколько распространенных форм гемолитической анемии:
- Аутоиммунная анемия. Это приобретенное заболевание, сопровождается обширным поражением клеток крови. Основная причина патологии — формирование антител в эритроцитах, которые провоцируют гемолиз. Аутоиммунные гемолитические анемии наблюдаются, если клетки иммунитета воспринимают красные кровяные тельца организма, как чужеродных агентов и стремятся их истребить. Прогноз такого заболевания неблагоприятный, требуется переливание крови или пересадка костного мозга.
- Анемия Минковского-Шоффара (наследственный микросфероцитоз) характеризуется аномальной проницаемостью эритроцитной мембраны, через которую проходят ионы натрия. Заболевание имеет аутосомно-доминантный наследственный характер. Развитие волнообразное: чередование стабильных периодов и гемолитических кризов. Основные признаки: уменьшение осмотической сопротивляемости эритроцитов, преобладание измененных эритроцитов — микросфероцитов, ретикулоцитоз. При сложном течении болезни необходимо хирургическое вмешательство (удаление селезенки).
- Талассемия. Если лечащий врач определяет врожденное заболевание крови талассемия, это следствие нарушенного продуцирования гемоглобина в химическом составе крови. Анемия при отсутствии своевременной терапии только прогрессирует, симптомы нарастают, превращают пациента в инвалида. Такая болезнь по происхождению является врожденной, требует сдачи комплекса анализов, подробного обследования клинического больного, лечения для поддержания периода ремиссии.
- Порфирии относятся к наследственной форме заболевания и обусловлены нарушением формирования порфиринов — составляющих гемоглобина. Первый признак — гипохромия, постепенно проявляется отложение железа, изменяется форма эритроцитов, в костном мозге появляются сидеробласты. Порфирии могут иметь и приобретенный характер при токсическом отравлении. Лечение осуществляется введением глюкозы и гематита.
- Серповидно-клеточная анемия является наиболее распространенным вариантом гемоглобинопатии. Характерный признак: эритроциты принимают серповидную форму, что приводит к застреванию их в капиллярах, вызывающему тромбоз. Гемолитические кризы сопровождаются выделением мочи черного цвета со следами крови, значительным снижением гемоглобина в крови, лихорадкой. В костном мозге обнаруживается большое содержание эритрокариоцитов. При лечении больному вводится повышенное количество жидкости, проводится оксигенотерапия и назначаются антибиотики.
Диагностика
В диагностике гемолитических анемий применяют общий клинический анализ крови (обнаруживается анемия и изменения размеров и формы эритроцитов), биохимический анализ крови (в том числе сывороточный билирубин, АлТ, ЛДГ), сывороточный гаптоглобин, гемосидерин и гемоглобин мочи. Для подтверждения диагноза могут применять пункцию костного мозга (в биоптате определяются активные процессы эритропоэза).
Наиболее характерным для активного интраваскулярного гемолиза является сфероцитоз эритроцитов (при трансфузионных реакциях, наследственном сфероцитозе, при гемолитической анемии с тепловыми антителами). Могут наблюдаться также шистоцитоз (при интраваскулярном протезировании, микроангиопатиях), серповидные эритроциты (при серповидноклеточной анемии), мишеневидные эритроциты (при патологиях печени, гемоглобинопатиях), ядросодержащие эритроциты и базофилия (при большой бета-талласемии).
Тельца Гейнца обнаруживаются при нестабильном гемоглобине, активации перекисного окисления, акантоциты — при анемии со шпоровидными эритроцитами, агглютинированные клетки — при болезни холодовых агглютининов.
Лечение гемолитической анемии
При развитти гемолитической анемии эффективное лечение намного сложнее, чем любых других ее видов. Это связано с тем, что повлиять на механизм запуска гемолиза не всегда возможно. Общий план лечебных мероприятий может включать в себя:
- Гемотрансфузии отмытых эритроцитов. Показано при снижении показателей красной крови до критических цифр;
- Применение препаратов фолиевой кислоты и витамина В12;
- Трансфузии свежезамороженной плазмы и человеческого иммуноглобулина;
- Введение глюкокортикоидных гормонов (дексаметазон, преднизолон, метилпреднизолон, кортинеф);
- Применение цитостатиков. Показано исключительно при аутоиммунной гемолитической анемии;
- Профилактика инфекционных осложнений и обострений имеющейся хронической патологии;
- Оперативное лечение в виде спленэктомии (удаления селезенки). Метод обеспечивает относительно неплохой прогноз на выздоровление. Не эффективен при анемии Минковского-Шоффара и других типах наследственного гемолиза.
Любая гемолитическая анемия, борьба с которой начата несвоевременно — сложная проблема. Недопустимо пытаться справиться с ней самостоятельно. Ее лечение должно быть комплексным и назначается исключительно квалифицированным специалистом на основании тщательного обследования пациента.
Приобретенная гемолитическая анемия
Основной группой препаратов, успешно применяемых в лечении приобретенного малокровия, являются глюкокортикоиды (преднизолон), которые способны полностью блокировать процесс гемолиза. Но лечение такими гормонами является довольно длительным. Для полной его эффективности требуется безошибочно рассчитанная дозировка препарата. При неэффективности стероидных гормонов применяются цитостатики.
Если же причину развития гемолитической анемии выявить не удается, то врачи приступают к симптоматическому лечению. Обычно оно заключается в переливании эритроцитарными взвеси пациенту. Особо эффективен этот метод при низком показателе гемоглобина (менее 50) и в периоды гемолитического прогрессирования.
Врожденная или наследственная анемия
Обычно медикаментозное лечение такой анемии дает только временные улучшения общего состояния больного, но рецидивы гемолитических кризов, к сожалению, не предупреждает. Здесь более эффективным будет оперативное вмешательство.
Оно подразумевает проведение спленэктомии — удаление селезенки. Данная операция показала 100%-ную эффективность, пациенты практически полностью излечиваются, хотя патологические свойства эритроцитов и сохраняются. Обычно показанием к операции являются приступы почечных колик, инфаркты селезенки, резкая форма анемии или часто повторяющиеся кризы.
Осложнения и профилактика
- ДВС-синдром;
- анемический шок (острая сердечно-сосудистая недостаточность);
- гемосидероз внутренних органов;
- подкапсульные разрывы, инфаркты селезёнки, гиперспленизм;
- арегенераторный криз;
- острая почечная недостаточность;
- дискинезии желчных путей.
Единственно возможным способом предупредить развитие анемии — ведение здорового образа жизни, своевременное лечение и профилактика других заболеваний.
Вопрос-ответ
Как проявляется гемолитическая анемия?
При гемолитической анемии проявляются общие симптомы, характерные для всех видов анемий (одышка, быстрая утомляемость, головокружение), а также специфические симптомы при гемолизе (потемнение мочи, иктеричность кожи и слизистых, спленомегалия). При многих формах гемолитических анемий может развиваться тромбоз.
Что такое гемолитическая анемия?
Гемолитическая анемия – это серьезное заболевание крови. Оно характеризуется преждевременным разрушением красных кровяных клеток. Это состояние сильно влияет на пациентов, поэтому точная диагностика и эффективное лечение крайне важны.
Как отличить гемолитическую анемию от железодефицитной?
Для подтверждения диагноза железодефицитная анемия необходим специфический лабораторный анализ на сывороточное железо. Гемолитическая анемия возникает в случае преждевременного разрушения эритроцитов.
Какие препараты вызывают гемолитическую анемию?
Лекарства для лечения приобретенной гемолитической анемии:
Преднизолон, таблетки 5 мг, 100 шт.
Метипред, таблетки 4 мг, 30 шт.
Дексаметазон, таблетки 0,5 мг, 56 шт.
Гепарин, раствор для внутривенного и подкожного введения 5000 МЕ/мл, 5 мл, 5 шт.
Советы
СОВЕТ №1
Обратитесь к врачу при первых симптомах. Если вы заметили усталость, бледность кожи или одышку, не откладывайте визит к специалисту. Раннее выявление гемолитической анемии может значительно улучшить прогноз и облегчить лечение.
СОВЕТ №2
Следите за своим рационом. Включите в меню продукты, богатые железом, витамином B12 и фолиевой кислотой, такие как красное мясо, рыба, яйца, бобовые и зеленые листовые овощи. Это поможет поддерживать уровень гемоглобина и улучшить общее состояние организма.
СОВЕТ №3
Избегайте саморазличных лекарств и добавок. Некоторые препараты могут усугубить состояние при гемолитической анемии. Перед началом приема любых новых медикаментов или добавок обязательно проконсультируйтесь с врачом.
СОВЕТ №4
Регулярно проходите медицинские обследования. Если у вас есть предрасположенность к гемолитической анемии или другие заболевания крови в анамнезе, регулярные анализы помогут контролировать состояние и предотвратить осложнения.